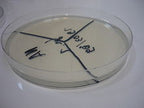
Nutriënt agar - Antonides -  Agar

Interchema | SKU:
I-Z3.110.66B
Nutriënt agar
Reguliere prijs
€6707 EUR
Eenheid prijs
Waarom bestellen bij Antonides?
✅Persoonlijk en betrouwbaar
✅Flexibel en op maat
Nutrientagar (NA) is een vast, microbiologisch groeimedium voor de routinekweek van aselectieve bacteriesoorten. Aangezien zeer weinig microben nutrientagar kunnen degraderen, blijft de agar vast tijdens het kweekproces.
-
Merk
Afbeeldingen dienen ter illustratie. Product kan afwijken van de getoonde foto.
Disclaimer
De chemicaliën in deze categorie zijn uitsluitend bedoeld voor professioneel laboratorium-, onderzoeks- of onderwijsgebruik door bevoegde organisaties en personen. Controleer vóór aankoop en toepassing altijd het meest recente veiligheidsinformatieblad (SDS), de lokale wet- en regelgeving (o.a. REACH, CLP, ADR) en de interne veiligheidsvoorschriften. Onjuist gebruik, opslag of verwijdering kan leiden tot ernstige gezondheids-, milieu- of materiële schade. Antonides aanvaardt geen aansprakelijkheid voor schade die voortvloeit uit onjuist of onveilig gebruik van de producten.
De chemicaliën in deze categorie zijn uitsluitend bedoeld voor professioneel laboratorium-, onderzoeks- of onderwijsgebruik door bevoegde organisaties en personen. Controleer vóór aankoop en toepassing altijd het meest recente veiligheidsinformatieblad (SDS), de lokale wet- en regelgeving (o.a. REACH, CLP, ADR) en de interne veiligheidsvoorschriften. Onjuist gebruik, opslag of verwijdering kan leiden tot ernstige gezondheids-, milieu- of materiële schade. Antonides aanvaardt geen aansprakelijkheid voor schade die voortvloeit uit onjuist of onveilig gebruik van de producten.